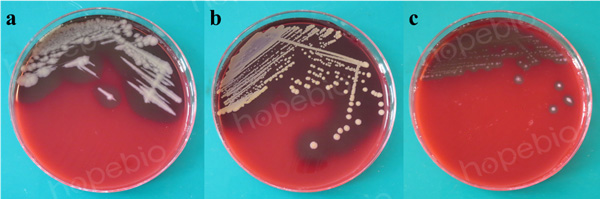
产品细节图片1

万千商家帮你免费找货
0 人在求购买到急需产品
- 详细信息
- 文献和实验
- 技术资料
- 库存:
999
- 保质期:
三个月
- 供应商:
青岛海博生物
- 规格:
9cm*10个/包
用途:用于细菌和真菌的培养、分离,不具有微生物鉴别和药敏鉴别的作用。
包装方式:一次性无菌塑料平皿 9cm
保存条件:2-8℃
运输条件:2℃-30℃条件下≤7天
产品备案号:鲁青械备20240285
生产备案号:鲁青食药监械生产备20150002号
成分(g/L)
| 蛋白胨 | 10.0 |
| 牛肉浸粉 | 5.0 |
| 牛心浸粉 | 3.0 |
| 酵母浸粉 | 5.0 |
| 玉米淀粉 | 1.0 |
| 氯化钠 | 5.0 |
| 琼脂 | 15.0 |
| pH值7.3±0.2 | 25℃ |
检验原理:
胰蛋白胨、大豆蛋白胨提供碳氮源、维生素和生长因子;氯化钠维持均衡的渗透压;脱纤维羊血提供丰富的营养物质;琼脂是培养基的凝固剂。
血液琼脂基础微生物质控结果:
a:蜡样芽孢杆菌,b:金黄se葡萄球菌,c:乙型溶血性链球菌
血琼脂培养基(医疗)(9cm)微生物灵敏度试验:
接种以下质控菌株,放置30-35℃需氧培养18-24小时。

风险提示:丁香通仅作为第三方平台,为商家信息发布提供平台空间。用户咨询产品时请注意保护个人信息及财产安全,合理判断,谨慎选购商品,商家和用户对交易行为负责。对于医疗器械类产品,请先查证核实企业经营资质和医疗器械产品注册证情况。
文献和实验相关专题 多姿多彩的琼脂 成分 pH7.4~7.6豆粉琼脂 100mL 脱纤维羊血(或兔血) 5~10mL 制法 加热溶化琼脂 ,冷至50℃,以灭菌手续加入脱纤维羊血,摇匀,倾注平板。亦可分装灭菌试管,置成斜面。亦可用其他营养丰富的基础培养基配制血琼脂。
实验大纲 骨髓间充质干细胞是多能干细胞。因此,作为再生医学的细胞来源,它是活性研究和临床应用的目标。当骨髓液或骨髓细胞接种在培养皿上时,间充质干细胞会作为粘附细胞增殖。因此,间充质干细胞可以从漂浮的血细胞中分离出来。在此,我们报告了使用 Evident Prov CM20 培养监测系统对间充质干细胞原代培养的远程监测结果。 试验程序 使用补充了 10% 胎牛血清(FBS)和 1% 青霉素链霉素的 Iscove 改良 Dulbecco 培养基(IMDM),将市售人骨髓细胞以 950,000
- - - - - - - - - 1mM Trolox - - - - - - - - - 1μM 一、hPSC 培养 1、将 hPSC 接种在 Vitronectin 包被的 6 孔板上,加入 hPSC 培养基进行扩增培养。 2、传代时加入 Accutase,将 hPSC 消化成单细胞。 3、用 DPBS 清洗两次后,接种到用 Vitronectin 包被的 12 孔板中,接种密度为 1.0 × 104 个细胞/cm2。 4、在传代培养的第一天加入含 10
技术资料暂无技术资料 索取技术资料










